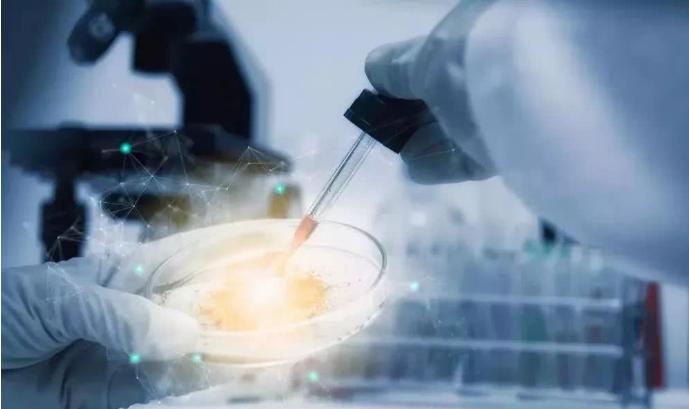
半月板损伤干细胞,半月板损伤干细胞注射液价格

当前交通伤害和运动伤害是膝关节半月板损伤的主要原因。膝关节半月板损伤后,不仅会发生关节机械阻塞,而且还会引起典型的临床症状和关节功能障碍,严重影响人们的生活和工作,甚至导致运动员竞技体育事业的终结。

数据显示:我国半月板损伤患者约5000万人,发病率逐年升高,且呈年轻化趋势,已成为导致我国中老年人群功能残疾主要疾病之一。
半月板损伤难修复,易诱发骨关节炎
半月板是膝关节的重要解剖结构,是位于胫骨平台与股骨内外髁之间的楔形纤维软骨组织。作为人体重要的运动承载部分,半月板在日常运动、行走时都会承受垂直载荷的压力和负担,一旦这些力产生失调,便容易导致半月板损伤。
半月板损伤是目前临床上较为常见的撕裂伤,中老年人由于组织学的粘液变性更易出现退变性撕裂;而年轻人多因剧烈运动或运动不当导致急性外伤撕裂。

半月板损伤导致患者的膝关节不能被稳定的固定,甚至诱发骨关节炎,患者的膝关节往往不能正常的作屈伸活动还有旋转活动,可能会使患者在行走时跌倒、摔跤。
研究数据显示:我国半月板损伤患者约5000万人,发病率逐年升高,且呈年轻化趋势,21—30岁年龄段患者若有明确外伤史,多由剧烈运动损伤所致;31—40岁年龄段患者若无明确外伤史或有轻微外伤,则多为慢性损伤。骨性关节炎已成为导致我国中老年人群功能残疾、严重影响生活质量和工作效率主要疾病之一。
干细胞治疗半月板损伤效果显著
在武汉同济医院,一位43岁的女性患者因半月板修复开心到“起飞”。就在一个星期前,该患者还因半月板损伤疼痛难耐,日常行走都需要依靠拐杖和轮椅。
正是接受了国家干细胞资源库团队研发的干细胞药修复半月板损伤后,患者逐步恢复了半月板功能。 该团队开发的“半月板损伤干细胞注射液”作为中国首个多能干细胞来源的细胞药物,将填补半月板治疗领域空白,走进寻常百姓家。

近年来间充质干细胞(MSCs)成为修复半月板损伤临床研究的热点。因其具有多潜能分化的特性,可同时向纤维软骨和关节软骨分化,且有强大的增殖能力,可以用于治疗退行性疾病。当干细胞注入患者关节后,在半月板损伤部位抑制软骨凋亡,分泌生长因子促进细胞增殖和半月板再生,进而从源头上解决半月板损伤问题。在临床应用上拥有较好的前景。
世界首例临床研究(ES来源功能细胞)
2019年1月9日,世界首例人胚胎干细胞分化功能细胞治疗半月板损伤在华中科大同济医学院附属同济医院顺利完成。该研究根据《干细胞临床研究管理办法(试行)》(国卫科教发〔2015〕48号)要求完成国家卫健委和食药监局备案。

目前,已有18名受试者接受了膝骨关节腔内注射干细胞。随访中,细胞移植过程中和移植后受试者生命体征平稳、活动不受限,患者在影像学上已有明显改善。
该临床研究首次使用了由人胚胎干细胞体外定向分化获得的功能细胞治疗半月板损伤,“半月板损伤干细胞注射液”就是其中的一种。
由于临床患者急需,半月板损伤干细胞注射液的获批和上市意义重大,不仅能够治疗病痛,惠及更多患者,还可以减轻医疗费用负担。未来药物获批后,干细胞注射液将作为处方药走进各大医疗机构。到时老百姓都能用上,用得起,其应用前景广阔。